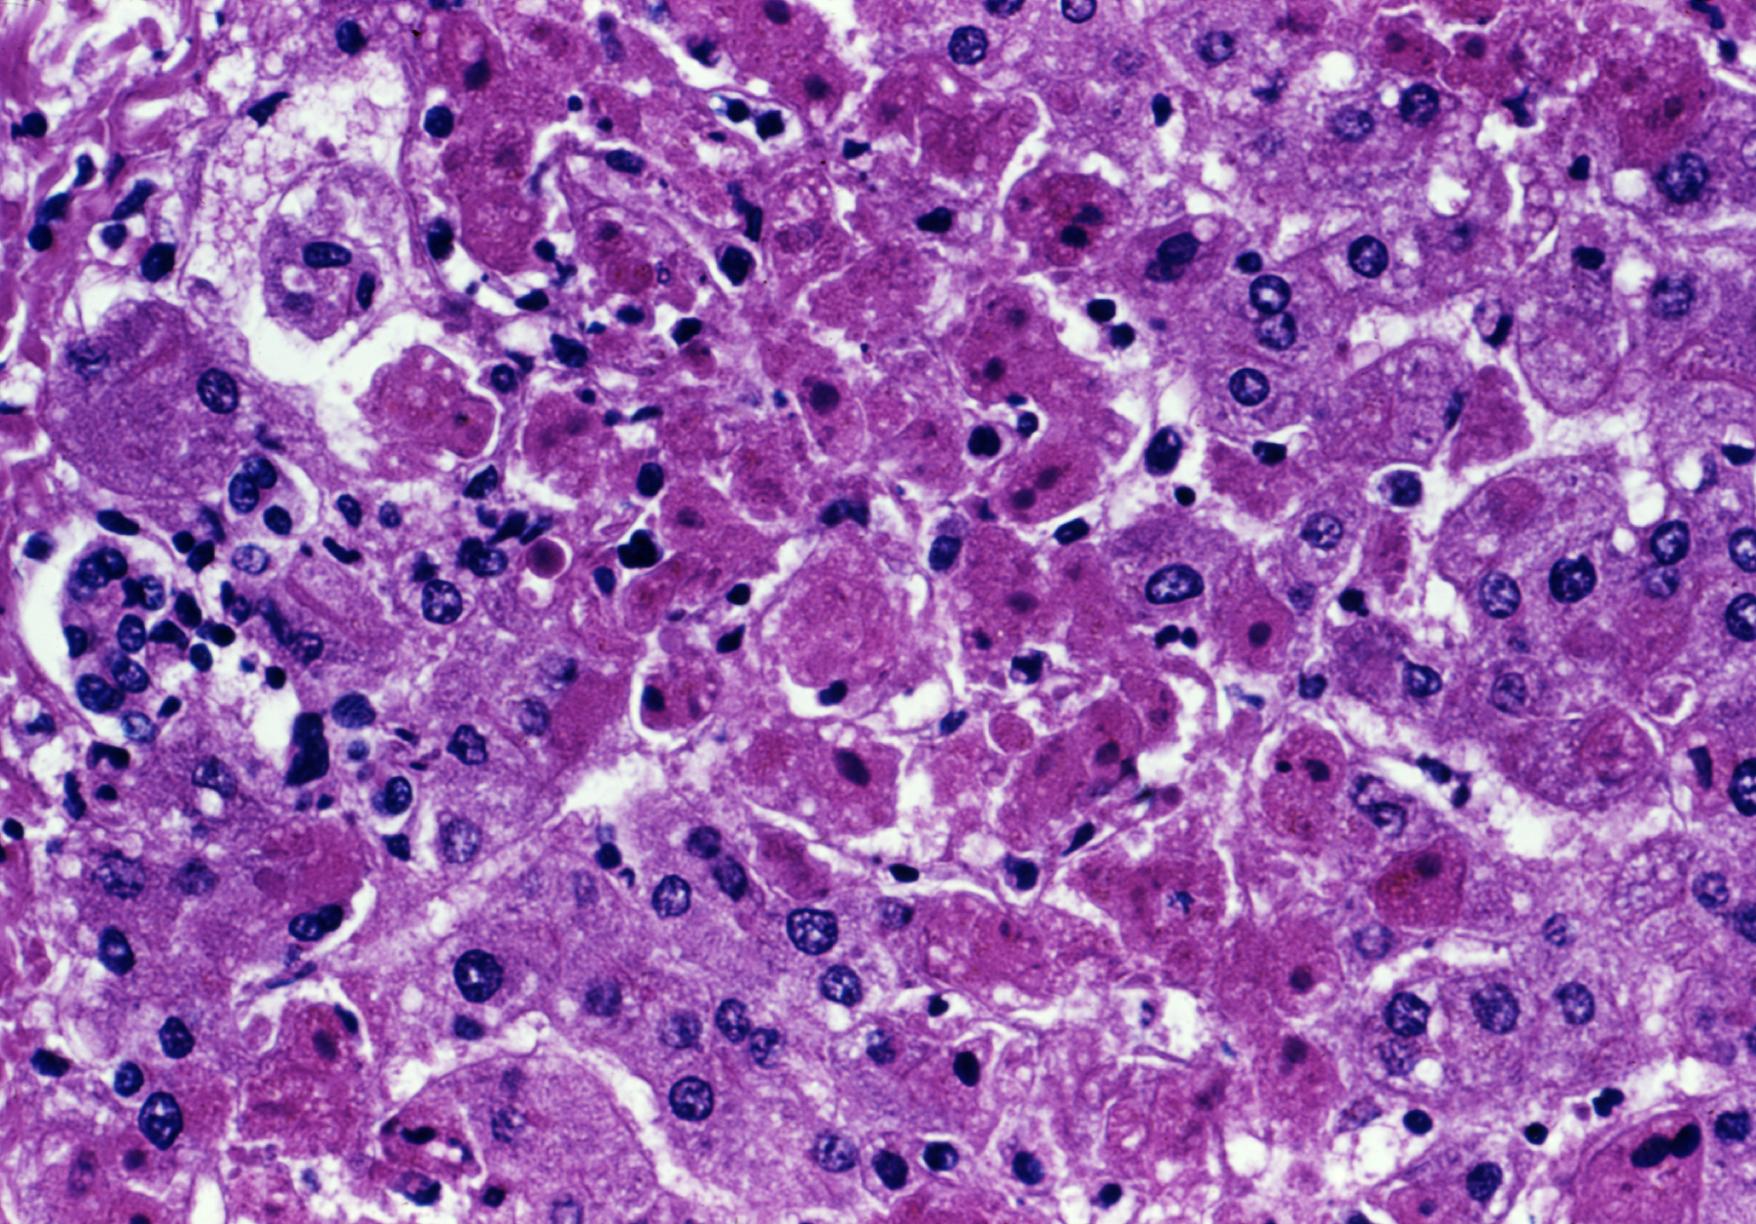

Epidemie
L’OMS convoca una riunione «urgente» sul virus letale Marburg
L’Organizzazione Mondiale della Sanità (OMS) ha convocato una «riunione urgente» la scorsa settimana riguardo ad un focolaio africano del virus Marburg, uno dei virus più letali al mondo.
I funzionari OMS affermano che Marburg, visto per la prima volta alla fine degli anni Sessanta, sarebbe correlato all’Ebola. Tuttavia, affermano altresì che esso è molto più mortale, uccidendo oltre l’88% delle persone che lo contraggono.
Il virus è stato rilevato in diversi paesi africani negli ultimi mesi, tra cui recentemente in Guinea Equatoriale. Un piccolo numero di casi di Marburg è stato trovato in Ghana alla fine dell’anno scorso.
“L’OMS martedì ha convocato una riunione urgente del consorzio per il vaccino contro il virus di Marburg (MARVAC) per discutere dell’epidemia”, scriveva lo scorso martedì un comunicato stampa OMS, aggiungendo che la Guinea Equatoriale ha confermato il suo primo caso di infezione il virus.
I funzionari dell’OMS affermano che il virus è responsabile di nove morti nella piccola Nazione africana.
L’epidemia di Marburg si è concentrata intorno alla provincia di Kie Ntem, situata nella Guinea equatoriale occidentale. I decessi sono avvenuti tra il 7 gennaio e il 7 febbraio, dice l’ente sanitario mondiale.
Nel suo comunicato, l’OMS ha affermato di aver inviato «squadre avanzate» nei distretti colpiti nel paese dell’Africa occidentale per fornire assistenza medica ed eseguire la ricerca dei contratti. «Le autorità sanitarie hanno inviato campioni al laboratorio di riferimento dell’Institut Pasteur in Senegal, con il sostegno dell’OMS, per determinare la causa», ha aggiunto il comunicato di martedì. «Sono stati testati otto campioni, uno dei quali è risultato positivo».
Come riportato da Renovatio 21, il focolaio del Marburg nell’Africa nera occidentale era già stato dichiarato dall’OMS nell’estate 2022.
A inizio anno a inventore dei moderni vaccini mRNA, il dottor Robert Malone aveva messo in guardia rispetto a una nuova malattia che si sta diffondendo nella Cina che sembra essere un super virus della «febbre emorragica simile all’Ebola».
La campagna di vaccinazione di massa del Partito Comunista Cinese «ha rispecchiato quella del mondo occidentale e ha portato a un tempesta ambientale perfetta per lo sviluppo di un super virus», aveva dichiarato il dottor Malone in una intervista con Steve Bannon.
«Stanno usando un linguaggio per cui questo sarebbe un virus della febbre emorragica. In tal caso, sarebbe molto strano che questo sia qualcosa causato da un coronavirus. Quella terminologia viene solitamente utilizzata per i virus della famiglia di Marburg ed Ebola».
Epidemie
Morti in casa anche per 8 giorni: emergenza ‘kodokushi’ tra gli anziani soli giapponesi

Renovatio 21 pubblica questo articolo su gentile concessione di AsiaNews. Le opinioni degli articoli pubblicati non coincidono necessariamente con quelle di Renovatio 21.
Secondo l’Agenzia nazionale di polizia, nel primo semestre del 2025 sono stati oltre 40mila in Giappone i casi di morte isolata in casa. Il 28% viene scoperto dopo più di una settimana. Tra le cause: invecchiamento della popolazione, indebolimento dei legami, riluttanza a chiedere aiuto. Padre Marco Villa, responsabile di un centro d’ascolto a Koshigaya: «Una persona mi ha appena detto: mi è rimasto un solo amico, ci sentiamo due volte all’anno… La solitudine il dramma più grande di questo Paese».
Kodokushi (孤独死): la morte in casa di persone circondate da una profonda aridità relazionale, che non viene scoperta anche per un lungo periodo di tempo dopo il decesso. È uno dei drammatici volti della solitudine in Giappone. Secondo i nuovi dati dell’Agenzia nazionale di polizia diffusi oggi, in Giappone solo nel primo semestre del 2025 sono stati 40.913 i decessi avvenuti in isolamento nelle abitazioni.
Una cifra che segna un aumento di 3.686 casi rispetto allo stesso periodo del 2024. Ma il dettaglio forse più inquietante è che almeno il 28% di essi (11.669 persone) è stato scoperto dopo almeno 8 giorni.
Iscriviti alla Newslettera di Renovatio 21
Una delle principali cause è anzitutto l’invecchiamento della popolazione del Giappone: 1 persona su 4 ha più di 65 anni. «Inoltre, si tende sempre più a non avere legami significativi né con il territorio, né con la famiglia. La maggioranza della gente non vive nei luoghi dove è cresciuta, ma si trova a vivere dove c’è lavoro», spiega ad AsiaNews dal Giappone padre Marco Villa, missionario del PIME che opera a Koshigaya, cittadina nella periferia nord di Tokyo, nella diocesi di Saitama. «Quindi, si fa più fatica a intrecciare relazioni significative con gente che non si conosce. Ciò accade anche perché avere relazioni a volte è davvero una cosa faticosa, allora si decide di non impegnarsi».
Padre Marco Villa nel 2012 ha favorito la nascita a Koshigaya del Centro d’Ascolto Mizu Ippai («un bicchiere d’acqua») – di cui è responsabile – proprio con l’obiettivo di sostenere le persone affette dalla solitudine, comprese le persone hikikomori, che soffrono di isolamento patologico ed estraniamento. Nel suo servizio non è raro che venga a conoscenza di casi di kodokushi, l’ultimo solo pochi mesi fa. «Una signora che frequenta il centro è rientrata a casa la sera, dopo un incontro. Dopo circa due settimane, il figlio mi ha chiamato dicendo che non aveva contatti con la mamma, chiedendo se l’avessi sentita. È andato a vedere se si trovava a casa, e l’ha trovata morta», racconta p. Marco Villa.
Questo caso dimostra che anche le persone che riescono a curare dei legami, a uscire di casa, possono andare incontro a una morte isolata. «Vivendo da sola si è imbattuta in questi rischi», dice Villa. Rischi che aumentano in quelle persone che, invece, vivono una solitudine più estrema, perché non hanno dei familiari vicini, o perché non hanno degli amici.
Padre Marco Villa racconta anche di una telefonata avuta poco prima di essere contattato oggi da AsiaNews. «Una persona mi ha detto che è morto un suo amico; ora gli rimane un amico solo, che sente due volte all’anno: una per gli auguri di compleanno e una per gli auguri di buon anno. È l’unico amico che ha: mi ha chiesto di passare del tempo insieme. Queste sono situazioni che incontro regolarmente», aggiunge.
Oltre alla significativa quota di persone anziane in Giappone, favorisce il preoccupante fenomeno kodokushi anche «la ritrosia della persona giapponese a chiedere aiuto». Villa spiega che, culturalmente, nel domandare è insita «la preoccupazione di dare fastidio agli altri, di non voler dare preoccupazioni a causa delle proprie difficoltà».
La tendenza rilevata è la gestione in totale autonomia dei problemi personali. Ciò affievolisce inevitabilmente i legami con le persone della famiglia, così come con coloro che vivono nello stesso luogo. Un elemento che il missionario definisce «costante», basandosi sulla sua esperienza in Giappone. «La solitudine è il dramma principale del Paese», dice.
Iscriviti al canale Telegram
Padre Marco Villa ammette di essere rimasto «sconvolto» dai casi di solitudine profonda incontrati nel Paese. Da questo sentimento nacque il Centro d’Ascolto Mizu Ippai di Koshigaya. «Chiesi al vescovo (della diocesi di Saitama, ndr) di poter iniziare un’attività a tempo pieno per cercare di alleviare la solitudine delle persone», racconta. Il Centro mette in campo le risorse del «volontariato dell’ascolto»: non professionisti all’opera, ma volontari e volontarie che offrono il proprio ascolto, nella struttura, così come alla stazione ferroviaria, luogo di aggregazione per la presenza di numerosi negozi.
Un’attività che affianca le iniziative istituzionali. «Lo Stato è consapevole di queste situazioni e cerca di essere sempre più capillare nel territorio attraverso strutture dedicate, cercando di creare delle occasioni di incontro per la gente. Questo è un tentativo, secondo me valido, che il Giappone porta avanti», spiega.
Come invertire la tendenza di questa drammatica e così diffusa esperienza umana? «La cosa fondamentale è creare delle occasioni di incontro, dei luoghi adatti per potersi trovare; fondamentalmente cercando di diventare amici delle persone che vivono in stato di solitudine», dice padre Marco Villa.
Solitudine che in alcuni casi viene «risolta» da lunghi dialoghi intrattenuti con l’intelligenza artificiale. «Ieri un ragazzo mi diceva che l’AI è l’unica persona che lo capisce, che riesce a capire i suoi problemi. Così crede di avere qualcuno, qualcosa con cui si relaziona, che però non è certamente un essere umano», aggiunge.
Per uscire da queste situazioni, ne è convinto il missionario, «basta poco: una via, una linea, un aggancio, capace di instaurare un minimo di relazione umana».
Invitiamo i lettori di Renovatio 21 a sostenere con una donazione AsiaNews e le sue campagne.
Renovatio 21 offre questo articolo per dare una informazione a 360º. Ricordiamo che non tutto ciò che viene pubblicato sul sito di Renovatio 21 corrisponde alle nostre posizioni.
Iscriviti alla Newslettera di Renovatio 21
Epidemie
Aumento delle infezioni da sifilide in Germania, soprattutto tra gli omosessuali

Aiuta Renovatio 21
Iscriviti alla Newslettera di Renovatio 21
Epidemie
L’ameba mangia-cervello uccide 19 persone in India

Lo Stato indiano del Kerala, nel Sud del Paese, sta affrontando una crisi sanitaria in escalation a causa di un’epidemia di meningoencefalite amebica primaria (PAM), causata dall’ameba «mangia-cervello» la Naegleria fowleri.
Le autorità hanno confermato giovedì che l’infezione ha provocato 19 morti e decine di casi, colpendo persone di età compresa tra i tre mesi e i 91 anni, rendendo difficile individuare fonti di esposizione comuni o contenere la diffusione.
La PAM, generata da un’ameba presente in acque dolci calde e nel suolo, penetra nel corpo attraverso il naso, attaccando il tessuto cerebrale e causando un’infiammazione potenzialmente letale in pochi giorni.
Il ministro della Salute, Veena George, ha definito la situazione una «grave emergenza sanitaria». Intervistata da NDTV News, ha spiegato: «Non si tratta di focolai legati a un’unica fonte d’acqua, come in passato, ma di casi isolati, il che complica le indagini epidemiologiche».
Iscriviti alla Newslettera di Renovatio 21
La George ha poi evidenziato l’importanza di una diagnosi precoce: «Il nostro tasso di sopravvivenza del 24% è ben superiore alla media globale, inferiore al 3%, grazie a interventi tempestivi e all’uso del farmaco miltefosina».
Un medico governativo, parlando con l’agenzia AFP, ha confermato che, nonostante il numero limitato di casi, «sono in corso test su vasta scala per identificare e trattare i contagi». Le autorità hanno intensificato le misure di controllo sull’igiene delle acque, invitando la popolazione a evitare fonti d’acqua dolce stagnanti o non trattate.
Secondo un rapporto governativo citato da News18, la PAM colpisce principalmente il sistema nervoso centrale, con un impatto sproporzionato su bambini, adolescenti e giovani adulti sani. Gli esperti chiariscono che l’infezione non avviene ingerendo acqua contaminata, ma attraverso il contatto con le vie nasali durante attività come nuoto o immersioni in acque non sicure.
Il lettore di Renovatio 21 conosce la minaccia dell’ameba mangia-cervello con dovizia.
Come riportato da Renovatio 21, l’anno passato un cittadino dello Stato americano della Georgia era morto per infezione dell’ameba mangia-cervello. Ancora più recente il caso di un giovane che è morto di encefalite in Israele pochi giorni dopo aver contratto l’ameba Naegleria fowleri.
Si trattava all’epoca della terza persona a morire negli Stati Uniti in un solo anno a causa della mostruosa creatura microscopica, che pare diffondersi sempre più a Nord.
Uno studio del CDC pubblicato nel 2020, ha rilevato che cinque dei sei casi di meningoencefalite amebica primaria (PAM), come viene chiamata l’infezione cerebrale causata da Naegleria fowleri, si sono verificati durante o dopo il 2010.
Come riportato da Renovatio 21, nel 2022 un cittadino del Missouri e un bambino del Nebraska sono stati ammazzati dall’ameba mangia-cervello.
Aiuta Renovatio 21
Come riportato da Renovatio 21, due anni fa è emersa la rilevazione di vibrio vulnificus, cioè di un tipo di batteri «carnivori», nelle spiagge della Florida.
Negli ultimi 15 anni, una malattia neurodegenerativa estremamente rara che mangia il cervello umano lasciando buchi è diventata sempre più comune in Giappone, ma il caso PAM statunitense sembra molto diverso.
Prioni sarebbero stati invece alla base di un’epidemia di cervi-zombie nel 2019.
Iscriviti alla Newslettera di Renovatio 21
Immagine di pubblico dominio CC0 via Wikimedia; rielaborata
-
Morte cerebrale2 settimane fa
La «morte cerebrale» è stata inventata per prelevare più organi
-
Arte2 settimane fa
Quadro su San Simonino da Trento, chiesti sei mesi di carcere per il pittore Gasparro
-
Persecuzioni5 giorni fa
Il ministro israeliano Katz: suore e clero cristiano saranno considerati terroristi se non lasceranno Gaza
-
Politica2 settimane fa
Il regista russo Tigran Keosayan muore all’età di 59 anni. Era il marito della temutissima Margarita Simonyan
-
Immigrazione1 settimana fa
Mons. Viganò: storia delle migrazioni di massa come ingegneria sociale
-
Civiltà1 settimana fa
La lingua russa, l’amicizia fra i popoli, la civiltà
-
Salute2 settimane fa
I malori della 39ª settimana
-
Autismo1 settimana fa
Ecco il possibile farmaco per l’autismo: che cos’è il Leucovorin?